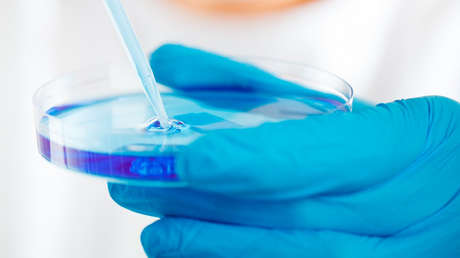
Una actriz se inyecta una bacteria de 3,5 millones de años en busca de la eterna juventud (VIDEO)

La actriz de 45 años que prefiere que la llamen Manoush reside en Alemania y ya ha gastado 50.000 dólares en cirugías plásticas en intentos por conservar su belleza juvenil. Este año ha dado otro paso en su intención de detener el envejecimiento, algo que considera "una enfermedad", y hace tres meses que se inyecta una bacteria de 3,5 millones de años, informa Barcoft TV.
La cepa bacteriana milenaria Bacillus F fue descubierta en el permafrost de la lejana Siberia, en la república rusa de Sajá, en 2009. Los científicos que desbloquearon su ADN en 2015 destacaron que no muestra indicios de envejecimiento y podría ser clave para mejorar la salud y aumentar la longevidad de los humanos.
Manoush, que desempeñó papeles en películas de terror como 'Cannibal' o 'Seed 2', recibió la bacteria de manos del científico ruso Anatoli Brushkov, pero se la inyecta sola en el flujo sanguíneo desde el 22 de julio, ya que el procedimiento se considera experimental y ningún médico se atrevería a inyectársela por poder perder su licencia. Cada mes le hacen pruebas de sangre y las comparan con las pruebas de antes.
La actriz afirma que nunca se ha sentido mejor y que su piel ha mejorado notablemente. Aunque se da cuenta de que esto no le ayudará a rejuvenecer 20 años, cree que le ayudará a vivir hasta los 80 o los 90. "Mi piel es tan suave como la cola de un bebé", reveló la mujer, quien también atribuye a los efectos de las inyecciones el hecho de que ahora padece menos resfriados.
Manoush no encuentra apoyo entre sus familiares, pero sí entre algunos amigos capaces de comprenderla. "Quiero morir con el pleno funcionamiento de mis funciones corporales y si esto ayuda, todo habrá valido la pena", sostuvo.
Anatoli Brushkov, quien encabeza el departamento de Geocriogenia de la Universidad Estatal de Moscú, se inyectó Bacillus F en 2015, pero ahora afirma tomarla por vía oral y destaca resultados positivos, aunque subraya que le aconsejó a Manoush que no se la inyectara.
Brushkov asegura que la zona donde hallaron la bacteria tiene fama de que los residentes locales son los que más viven en Siberia y explica que "consumen esta bacteria en el agua cuando el permafrost se derrite y en el agua aparecen los microrganismos".
"Estos microrganismos poseen una especie de mecanismo sorprendente que los mantiene vivos a lo largo de millones de años. Imagínense si fuéramos capaces de utilizarlo y prolongar nuestras vidas por miles de años", sostuvo el científico ruso.
Hasta la fecha, los únicos seres humanos en ingerir Bacillus F han sido Brushkov y Manoush. Previos informes evidencian efectos positivos en casos de inyecciones en organismos vivos, como las células sanguíneas de los humanos, ratones, moscas de fruta y cultivos. Brushkov está seguro de que "tenemos en nuestras manos algo vivo en la Tierra que vive millones desde hace años" y que "no deberíamos perder esta oportunidad".